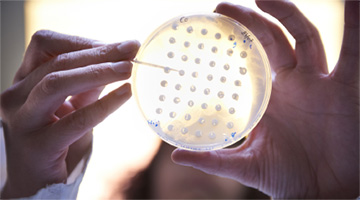

.01
SOCIÉTÉ
RÉPONDRE AUX DEFIS DE LA CHIMIE GRÂCE À L'INGENIERIE BIOLOGIQUE
Alderys développe des approches innovantes d’ingénierie biologique des microorganismes pour produire des composés chimiques d’intérêt économique à partir de ressources végétales renouvelables. Portés par une démarche scientifique imaginative et forte, nous améliorons les cellules de levure pour les transformer en véritables micro-usines de production. Nos procédés offrent de nouvelles solutions technologiques industrielles, respectueuses de l’environnement, pour la fabrication de produits indispensables à notre monde en croissance.
Les programmes développés par Alderys ciblent les marchés de la chimie de commodité, de la cosmétique et de la nutrition animale . Grâce à la qualité et l’innovation de ses technologies, Alderys a conclu plusieurs accords de partenariats avec des acteurs industriels majeurs.

> NOTRE SOCIÉTÉ
UN PROCESSUS NATUREL MULTIMILLÉNAIRE
L’homme utilise les levures pour son alimentation depuis qu’il fabrique du pain, de la bière et du vin. Il exploite ainsi la capacité naturelle des levures à fermenter des sucres pour produire de l’alcool et du gaz. Les caractéristiques génétiques des souches de levures sont sélectionnées par l’homme depuis plus de quatre millénaires, afin d’adapter le goût ou la productivité. Dans une version moderne et accélérée de ces procédés, Alderys depuis son lancement opérationnel en janvier 2011, construit et sélectionne de nouvelles souches de levures. Celles-ci sont capables de produire des composés d’intérêt économique pour des marchés variés, allant de la a chimie de commodité, à la cosmétique, en passant par la nutrition animale. Les procédés de bio-production développés par les équipes d’Alderys ciblent des marchés mondiaux représentant plusieurs milliards à plusieurs centaines de millions d’euros.
UNE BIO-PRODUCTION INDUSTRIELLE CIBLÉE
En s’appuyant sur un système propriétaire d’exploitation de données, les scientifiques d’Alderys imaginent les souches de levures adaptées à la production de chaque produit cible. Grâce à une technologie de pointe, les modifications nécessaires à la transformation des levures en véritables micro-usines de bio-production sont exécutées rapidement. Les combinaisons de modifications les plus productives sont ensuite sélectionnées pour entrer en phase de production. Le champ d’applications des procédés d’Alderys pour la bio-production de composés à l’échelle industrielle est très large. Il peut s’agir de molécules naturellement produites par la levure. Dans ce cas, Alderys utilise un savoir-faire spécifique qui lui permet d’augmenter la productivité de ces levures et leurs rendements de production. Les équipes d’Alderys appliquent également leur talent au développement de procédés de bio-production de molécules qui n’étaient jusqu’à présent synthétisées que par voie chimique.

UNE ALTERNATIVE DURABLE À LA PÉTROCHIMIE
L’approche d’Alderys lui permet de proposer aux industriels de la pétrochimie une alternative compétitive aux procédés actuels. Outre leurs avantages technologiques, les procédés alternatifs développés par Alderys s’inscrivent dans une logique d’économie durable et renouvelable. L’utilisation de micro-organismes capables de transformer les sucres non alimentaires et les déchets végétaux en composés chimiques d’intérêt rend compatibles les objectifs de performance économique et de respect de l’environnement.
En développant des procédés efficaces de bio-fermentation, Alderys offre aux industriels des alternatives viables et pérennes pour des marchés mondiaux majeurs. Alderys leur permet ainsi de substituer des matières premières fossiles par des matières végétales et des processus de synthèse chimique par des procédés de chimie biologique.
Alderys vise des marchés d’importance économique majeure. La pétrochimie demeure en effet une source de production d’un nombre élevé de produits manufacturés courants: plastiques, élastomères, fibres synthétiques, peintures, solvants …. sont aujourd’hui fabriqués à partir de pétrole.
Alderys a choisi de limiter ses domaines d’intervention aux composés nécessaires à la nutrition animale, la santé et certaines filières de la chimie de commodité. La stratégie de développement de la société repose également sur l’analyse des modifications récentes du marché du pétrole où l’émergence des gaz de schistes a considérablement modifié les filières d’approvisionnement de certains composés chimiques majeurs.
La capacité à répondre à un besoin, la création de valeur, le potentiel et la faisabilité des approches pouvant être conçues par les équipes d’Alderys constituent également des éléments déterminants des choix de développement de la société.
Depuis son lancement opérationnel en janvier 2011, grâce à la qualité de ses approches innovantes et à la démonstration de ses capacités d’exécution, Alderys a établi des contrats de partenariat avec cinq acteurs industriels majeurs, leaders mondiaux sur leurs marchés.


> ORGANISATION
Dès sa création, Alderys s’est structurée de manière à optimiser le développement de procédés de bio-production. La société est organisée en départements spécialisés qui constituent des unités indépendantes et qui collaborent pour fournir les ressources technologiques nécessaires au développement de chaque procédé. Cette organisation matricielle permet la coordination des travaux à effectuer tout en mobilisant de manière ciblée les meilleures compétences de chaque scientifique d’Alderys.
DÉPARTEMENT D'INGÉNIERIE GÉNOMIQUE
Ce département exploite l’ensemble des outils informatiques et techniques de G-DESIGNER, la plateforme d’ingénierie génomique propriétaire d’Alderys, pour concevoir et construire les souches microbiennes innovantes requises pour chaque procédé. Le département d’Ingénierie Génomique d’Alderys possède les plus hautes compétences en biologie moléculaire et génétique qui sont requises pour l’implémentation de nouvelles fonctions métaboliques au sein de cellules microbiennes. L’utilisation de procédures standardisées, développées grâce à l’expérience des scientifiques d’Alderys, optimise l’exécution de l’ensemble des plans expérimentaux. Les travaux du département d’Ingénierie Génomique sont accélérés grâce à l’automatisation d’étapes clefs de construction moléculaire. L’élaboration de nouvelles souches microbiennes et de levures est extrêmement efficace : le département d’Ingénierie Génomique produit environ 450 nouvelles souches innovantes chaque trimestre.


DÉPARTEMENT DE CHIMIE BIOLOGIQUE
Le Département de Chimie Biologique prend en charge les caractérisations biochimiques et métaboliques des souches innovantes lorsque les étapes d’ingénierie génomique et de validation moléculaire sont achevées. A cette fin, le département mobilise l’ensemble de ses équipements technologiques sophistiqués et de leurs capacités analytiques. Le département dispose de plusieurs spectromètres de masse, combinés à des appareils de chromatographie liquide ultra-haute performance, des systèmes de chromatographie gazeuse et des spectromètres infra-rouge. Ces équipements performants permettent de valider l’efficacité des nouvelles voies métaboliques implémentées dans les souches microbiennes, de cribler des variants enzymatiques selon leur activité ou leur spécificité. Le département de Chimie Biologique détermine les rendements et les productivités associés à chaque souche ainsi que les taux de consommation des matières premières végétales. Ce département est également compétent en chimie organique ce qui lui permet de synthétiser des intermédiaires réactionnels ou des réactifs innovants nécessaires aux activités de la société.
DÉPARTEMENT DE ROBOTIQUE
Pour créer et caractériser rapidement des souches microbiennes innovantes, Alderys s’appuie sur une large automatisation de ses procédés d’ingénierie génomique. La société a associé plusieurs plateformes robotisées de manipulation de souches de levures et de souches microbiennes. La société a développé les algorithmes et les processus robotiques nécessaires pour assurer une automatisation performante de ses technologies. Le département de robotique gère les plateformes robotiques, les procédures informatiques associées et le traitement des données. Le département dispose de 5 plateformes robotiques principales ce qui lui permet de traiter chaque jour, en parallèle, plusieurs centaines de cultures. Cette approche haut-débit est couplée à des dispositifs de mesure variés utilisant la lumière visible, la fluorescence ou la luminescence. L’organisation du département robotique a été conçue pour offrir la plus grande souplesse d’emploi aux scientifiques d’Alderys. Grâce à la robotique, l’automatisation des procédés assure, au-delà de l’amélioration de la productivité, une meilleure traçabilité et reproductibilité des opérations de la société.


DÉPARTEMENT DE FERMENTATION
Au contraire des méthodes de synthèse chimique qui reposent souvent sur des procédés multi-étapes, les procédés de bio-production développés par Alderys n’impliquent qu’une étape unique, appelée fermentation. La fermentation constitue le procédé final qui, une fois industrialisé, permettra la transformation de molécules carbonées d’origine végétale en produits chimiques d’intérêt. Le département de fermentation développe et optimise cette étape. La plate-forme de fermentation d’Alderys est équipée de douze fermenteurs. Ils permettent de préciser les paramètres opérationnels de la fermentation et d’en ajuster les conditions aux futures contraintes de son déploiement à l’échelle industrielle. Les travaux de ce département permettent d’améliorer les productivités et les rendements de chaque procédé, critères dont la maitrise est primordiale pour assurer la compétitivité économique des procédés de bio-production. Le département de fermentation explore également l’utilisation de diverses sources carbonées non alimentaires pour chaque procédé développé, selon les demandes des partenaires industriels.

> MANAGEMENT

Le Dr. Dominique Thomas a été successivement Directeur de Recherche et médaille de bronze CNRS, Fondateur et CEO de Cytomics Systems (2000-2007), et Directeur Général l’incubateur technologique du plateau de Saclay, IncubAlliance (2007-2010). Auteur de plus de 50 publications dans des revues scientifiques de haut niveau, il combine cette expérience académique et entrepreneuriale avec de nombreuses collaborations pour l’industrie. Dominique Thomas possède un savoir-faire unique dans la manipulation industrialisée d’espèces microbiennes, l’implantation de nouvelles voies métaboliques chez la levure, et la manipulation robotisée d’espèces microbiennes. Dominique Thomas est Président Directeur Général et Directeur Scientifique d’Alderys.

Le Dr. Karine Jaillardon dirige le Département de Chimie Biologique d’Alderys. Elle supervise l’ensemble du travail de chimie organique, de synthèse et d’analyse de métabolites. Karine Jaillardon possède un doctorat en Chimie Organique de l’Université d’Orsay-Paris XI (2000) et a occupé différents postes de responsabilité au sein de grandes sociétés pharmaceutiques et de start-up. Elle était notamment Chef d’Equipe chez Cytomics Systems (2005-2010) et chez Entomed (2004-2005). Karine Jaillardon a également occupé des postes de Chercheur au sein de Fournier Pharma (2003-2004), Sanofi-Synthélabo (2003), et Maxia Pharmaceuticals (San Diego, 2000-2003).

Le Dr. Dominique Louis dirige le Département d’Ingénierie Génomique. Dominique Louis possède un doctorat de l’Université de Lyon I (1996). Auteur de plusieurs publications dans des journaux à comité de lecture, Dominique Louis a été auparavant Chef de Projet R&D chez Evologic (2001-2004) puis à l’Institut de Génomique du CEA à Evry (2004-2011). Dominique Louis a également occupé des fonctions de chercheur au Centre de Génétique Moléculaire du CNRS (Gif sur Yvette)

le Dr. Bruno Sargueil supervise les activités du département de Robotique d’Alderys. Co-fondateur de Cytomics Systems (2000-2010), Bruno Sargueil a préalablement été chercheur associé de l’université du Vermont -USA (1993-1995) puis de l’université de Cambridge – UK (1998-2000). Directeur de Recherches au CNRS, il dirige l’équipe « Mécanismes moléculaires de l’initiation de la traduction » au sein de l’Université Paris Descartes. Spécialiste des mécanismes de l’expression des protéines ainsi que de l’évolution des catalyseurs biologiques, Bruno Sargueil apporte à la société ses compétences en biologie et en développement de processus robotiques.